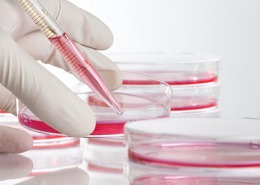

Kompetenz in allen Bereichen der Pferdemedizin
Schulmedizin
Die klassische Schulmedizin für Pferde arbeitet überwiegend symptombezogen. Die Vorteile: sie wirkt oft schnell und direkt.
Unsere Kompetenz erstreckt sich auf alle Bereiche der Pferdemedizin: Bewegungsapparat, Atmungstrakt, Herz-Kreislauf-System, Verdauungstrakt, Augen, Urogenitaltrakt, Infektionskrankheiten, Stoffwechselerkrankungen. Für Laboruntersuchungen bedienen wir uns spezialisierter Fremdlabors. Die routinemäßigen Proben werden jeden Abend von einem Kurierdienst abgeholt, die Ergebnisse liegen somit in der Regel am Folgetag vor.
Röntgenuntersuchungen, Ultraschalluntersuchungen sowie Bronchoskopie können dank der Verfügbarkeit mobiler Geräte und Anlagen direkt vor Ort mit einem endgültigen Ergebnis abgeschlossen werden.
Für Krankheitsfälle, die eine spezielle weiterführende Untersuchung benötigen, werden wir Sie zum richtigen Zeitpunkt an den richtigen Ort überweisen und anschließend gerne nahtlos den Patienten im Heimatstall wieder weiterbetreuen. Voraussetzung hierfür ist eine gute und offene Kommunikation mit den Überweisungs-Kliniken, nicht zuletzt, um keine Kosten für unnötig doppelt geführte Untersuchungen oder Behandlungen zu produzieren.
Dazu kommt unsere umfangreiche Beratung – manchmal stammen die Ursachen von Beschwerden auch von außen. Das kann eine falsche Ausrüstung sein, erlittene Traumata oder Reiterfehler. Nach der Anamnese weisen wir Sie ggf. auf solche Ursachen hin.